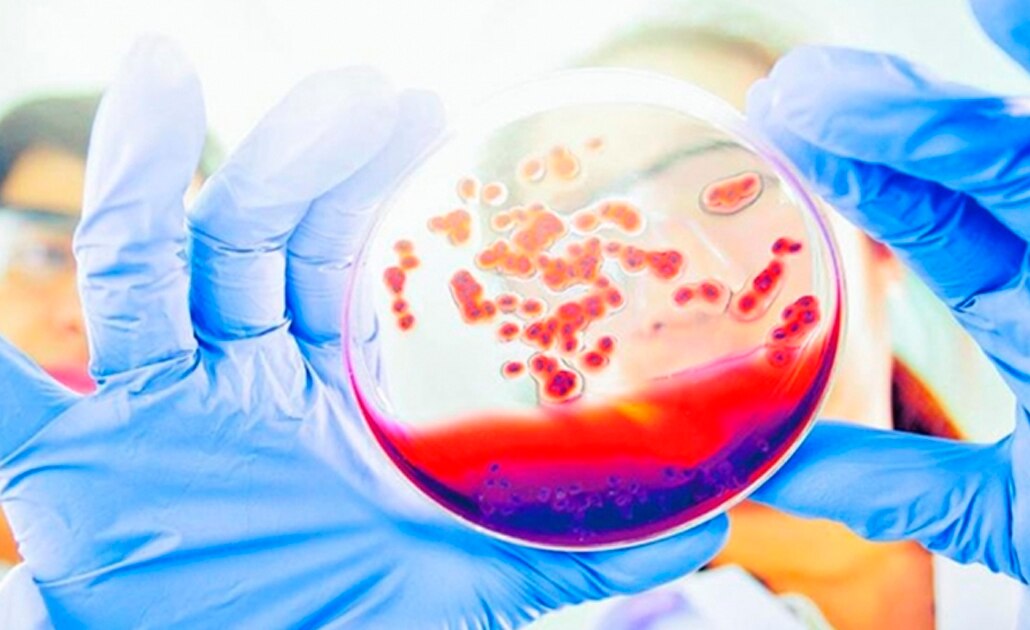
Foto: Especial

La secretaría Departamental de Salud del Valle, Colombia, alertó a padres de familia sobre un supuesto reto viral que circula en redes sociales. Según la denuncia de esa dependencia, jóvenes están siendo llamados a tener relaciones sexuales con personas que padezcan VIH/Sida.
“Unos padres de familia llamaron para informarme que estaba circulando a través de internet una invitación de personas que tienen VIH/Sida a tener contacto sexual con ellos. Se ubican en la ciudad, envían el transporte y les garantizan una pastilla del día después, con la advertencia de que se va a jugar un reto, pero que existe una posibilidad de que la enfermedad no se transmita”, explicó María Cristina Lesmes, secretaria departamental de Salud.
"Sí existe una píldora para evitar el contagio entre personas que tienen el virus, pero requiere días de toma y no es tan sencillo como tomársela el día después de un contacto sexual con una de estas personas", añadió Lesmes, ya que el riesgo de contagio continúa siendo alto.
También la funcionaria añadió que han encontrado en aumento el número de personas con VIH/Sida, especialmente en menores de 14 años y, asegura, se está poniendo en riesgo la vida de muchos niños y adolescentes que se encuentran con estas tendencias peligrosas en redes sociales.
“Nos están poniendo en riesgo la vida de los niños, adicionalmente, y no necesariamente como una causa efecto, hemos encontrado que el número de personas con VIH/Sida ha aumentado en el último periodo de tiempo, especialmente en los niños menores de 14 años, es decir, que tenemos un resurgimiento de esta infección que si bien hoy no es una enfermedad mortal, sino una enfermedad crónica, con el tiempo afecta la vida de las personas y limitará su existencia de muchas formas”, insistió María Cristina Lesmes.
La secretaria Departamental de Salud les recordó a los padres de familia que dentro de las responsabilidades del cuidado de los menores se encuentra la revisión de las redes sociales y la identificación de las personas con las que los jóvenes se relacionan.
[Publicidad]
Más información

Estado
Reconoce Protección Civil federal situación de riesgo en San Luis Potosí por incendios forestales

Política
PRI destaca a Enrique Galindo entre sus perfiles clave para las elecciones de 2027

Seguridad
Agentes de la Guardia Civil Estatal ya fueron vinculados a proceso por homicidio de 2 civiles en Matehuala, SLP

Política
Próxima semana llegaría Reforma Electoral al Congreso del San Luis Potosí, anticipa Ricardo Gallardo